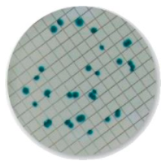
2326_Biorad_dish

Bio-Rad Laboratories manufactures innovative methods for the microbiological analysis of water. Those alternative methods are based on new technologies such as chromogenic media and real-time PCR.
This new generation of analytical methods enables simple analysis which are easy to implement, reliable and faster compared to classical methods. The performance of these methods is certified NF Validation by AFNOR and US EPA.
The iQ-Check Legionella solution is the first and only Legionella PCR method validated by a third party (NF validation according to ISO/TS 12869 and NF T90-471) that includes management of free DNA in the sample for all types of water and the use of CFX Opus Real-Time PCR Systems. Bio-Rad has recently launched XP-Design Assay L. pneumophila SG1 that utilizes real-time PCR technology to provide highly accurate identification of Legionella pneumophila serogroup 1 (SG1) in water samples. Products comply with regulatory standards and allow for risk management based on accurate and rapid results.
New methods for water analysis are often included in the standard reference method. In some countries where local regulations are permitted, alternative methods can be used for regulatory analysis.
Download our comprehensive Water Safety and Quality Reference Guide.
To learn more, visit our website or use the Request Information button below to send an email.
